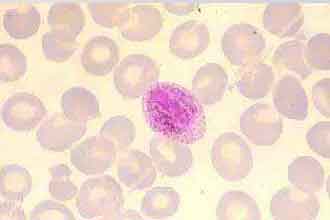
未标题-1.jpg

|
疟原虫疗法: 是观察性研究,还是干预性治疗?科技日报 2019-02-18 作者:张佳星 |
2月14日,疟原虫免疫疗法临床研究项目组宣布临床研究招募志愿者名额已满。有媒体记录了报名的火爆:百余人汇集到相关医院填写报名表。同时,有财经媒体指出:项目实施企业广州中科蓝华生物科技有限公司的控股股东、上市公司蓝盾股份其间股价大涨。
一个科学演讲引发了社会、经济的巨大波动,中国科学院广州生物医药与健康研究院研究员陈小平被推到了风口浪尖。
基于观察性研究,就能发布“暗示性”结论吗?
在中国临床试验注册中心的公开数据显示,与疟原虫免疫疗法相关的3个临床研究均为观察性研究。基于观察性研究的初步结果,陈小平在公众平台上通过演说的方式声称疟原虫免疫疗法可以治疗癌症。
“他发表的是一些非临床论文。”解放军总医院老年医学研究所所长王小宁表示,相关演说有些渲染的成分。观察性研究之后,仍需要进行动物实验、探求机理等研究活动,在获得足够的安全性、有效性证据之后,再开启真正的临床试验性研究,刊登临床论文是负责任的行为。而没有临床论文,意味着没有经过投稿、审稿过程的“沙里淘金”,难以评判该研究结论的真实有效。
合法合规?业内观点不一
王小宁认为,合规的临床试验应该经由CDE(国家药品监督管理局药品审评中心)批准,拿到临床批件。记者并未在CDE网站上检索到相关临床试验的信息公示。
虽然研究在中国临床试验注册中心获得注册号,但中国临床试验注册中心的实质是非赢利注册机构,与行政部门的批准不同,前者更侧重于信息采集。中心相关单位的专家也表示:“中心只具有注册职能,并不会对前来注册的试验进行审评。”
北京大学教授饶毅发表言论认为,对于群体来说,疟原虫免疫疗法使人患疟疾病后,有通过蚊子传染给其他人的潜在可能,有直接危险。
中科蓝华的网站上显示疟原虫免疫疗法的流程为:咨询、评估、接种、治疗期、灭虫、灭虫后检查、随访。但灭虫方法是否有效仍然存疑。有分析表示,所使用的治疗间日疟易潜伏于肝细胞内,难以灭除。事实上,有明确致病性的疗法很难通过伦理审查,并被批准临床。
是原创研究成果?创新性受质疑
为确保患者生命健康安全,项目组可以对使用病原进行一系列研究和改进,再应用于临床试验。例如,将疟原虫进行遗传改造,让它丧失致病能力,或通过基础研究,找到疟原虫能够激发机体非特异性免疫的真正机理,再创新治疗方法……
事实上,2017年国外研究人员曾从疟原虫体内分离出一种称为VAR2CSA的蛋白质,通过对其进行结构改造,获得的药物被证明可增强膀胱癌小鼠的生存期。
陈小平研究团队却用最“原始”的疟原虫直接上临床。多位学者表示,疟原虫蛋白为什么能激活NK细胞、是什么样的信号让NK细胞释放细胞因子,这些深入生命活动本质的机理问题尚未探究,就开始人体试验,是置患者生命健康于不顾的做法。
专家 点评
史晋海 中国蛋白药物质量联盟秘书长
在国际医药产品研究领域广泛接受的临床研究实践中,“观察性研究”是特指医学研究工作者只做观察,没有给予任何特定的干预性治疗(如新药物)的一类研究。如果患者接受注入疟原虫等非常规治疗方法,则不应当列入“观察性研究”。如果以观察性研究申请注册,而行干预性治疗(如疟原虫输入)验证之实,不仅违背临床试验申请初衷,也致使该研究不合规,不合法。
医师要有医德,科学家也自然要有“科德”,从事生命科学和医药产品研究的科学家则必须兼而有之。作为一名科学家,利用媒体传播不合规甚至不合法的“观察性研究”,给出“暗示性”结论,有违医德和药物科学评审的基本原则,也缺乏科学工作应有的严谨精神和基本训练。
利用感染性病原(细菌或寄生虫等)抗原性激活人体的非特异和特异性免疫系统治疗癌症,这样的思路在医学和科学界早已有之,如卡介苗治疗癌症。为确保患者生命健康安全,所使用的病原需要进行一系列的研究和改进,才能应用于临床试验。
责任编辑:杨茗
上一篇:研究人员发现上百种新的肠道细菌
下一篇:植物没有耳朵,却能"听见"声音?
 科普中国APP
科普中国APP
 科普中国微信
科普中国微信
 科普中国微博
科普中国微博

最新文章
-
为何太阳系所有行星都在同一平面上旋转?
新浪科技 2021-09-29
-
我国学者揭示早期宇宙星际间重元素起源之谜
中国科学报 2021-09-29
-
比“胖五”更能扛!我国新一代载人运载火箭要来了
科技日报 2021-09-29
-
5G演进已开始,6G研究正进行
光明日报 2021-09-28
-
“早期暗能量”或让宇宙年轻10亿岁
科技日报 2021-09-28
-
5G、大数据、人工智能,看看现代交通的创新元素
新华网 2021-09-28













